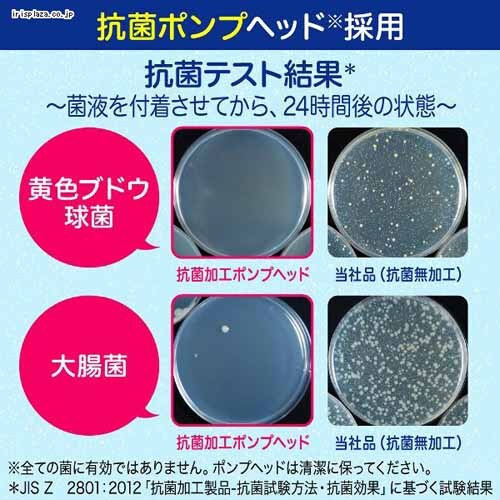

獲得予定ポイント
- 通常ポイント内訳
- お買い物ポイント
- 1倍
- 合計
- 7ポイント
獲得予定ポイント
- 通常ポイント内訳
- お買い物ポイント
- 1倍
- 合計
- 7ポイント
獲得予定ポイント
- 通常ポイント内訳
- お買い物ポイント
- 1倍
- 合計
- 7ポイント
獲得予定ポイント
- 通常ポイント内訳
- お買い物ポイント
- 1倍
- 合計
- 7ポイント
獲得予定ポイント
- 通常ポイント内訳
- お買い物ポイント
- 1倍
- 合計
- 7ポイント
獲得予定ポイント
- 通常ポイント内訳
- お買い物ポイント
- 1倍
- 合計
- 20ポイント
獲得予定ポイント
- 通常ポイント内訳
- お買い物ポイント
- 1倍
- 合計
- 18ポイント
獲得予定ポイント
- 通常ポイント内訳
- お買い物ポイント
- 1倍
- 合計
- 18ポイント
獲得予定ポイント
- 通常ポイント内訳
- お買い物ポイント
- 1倍
- 合計
- 18ポイント
- HOME
- イベント
- 【緊急開催】ゲリライベント
- Kao 【3個セット】ビオレu 泡ハンドソープ つめかえ用 770ml フルーツの香り【プラザセレクト】
商品をシェアする
Kao 【3個セット】ビオレu 泡ハンドソープ つめかえ用 770ml フルーツの香り【プラザセレクト】
リンクをコピーしました。
Kao 【3個セット】ビオレu 泡ハンドソープ つめかえ用 770ml フルーツの香り【プラザセレクト】
- 超目玉 超目玉
- ¥1,850(税込)
- 18ポイント
- (1倍)
- 超目玉 超目玉
- ¥1,850(税込)
- 18ポイント
- (1倍)
・殺菌成分配合で、汚れ、ウイルス・細菌を除去
・ノーマル(マイルドシトラス)・フルーツ・シトラスの香りの他に、無香性は手に香りが残らないので、色んなシーンに使えます
・大容量のつめかえ用
・医薬部外品
※製品は予告なく仕様を変更する場合がございます。あらかじめご了承ください。
●内容量:770ml(つめかえ用)
●商品サイズ(cm):幅約8.5×奥行約8.5×高さ約19.55
●成分:イソプロピルメチルフェノール*、水、ポリオキシエチレンラウリルエーテル硫酸アンモニウム(1E.O.)液、PG、エタノール、PEG6000、POEラウリルエーテル酢酸、グリセリルエチルヘキシルエーテル、アクリルアミド・アクリル酸・塩化ジメチルジアリルアンモニウム共重合体液、塩化トリメチルアンモニオヒドロキシプロピルヒドロキシエチルセルロース、エデト酸塩、乳酸、水酸化ナトリウム液、安息香酸塩、香料(無香性を除く)
*は「有効成分」 無表示は「その他の成分」
| JAN |
4901301416087 [シトラスの香り|単品]
4901301416001 [ノーマル|単品]
4901301416056 [フルーツの香り|単品]
4901301435026 [無香性|単品]
|
|---|
また、商品がメーカーにて完売となっていた場合、キャンセル又は注文内容の変更をお願いいたしております。
予めご了承くださいますようお願いいたします。 ■こちらの商品はアイリスプラザがセレクトしたオススメ商品です。

在庫切れ